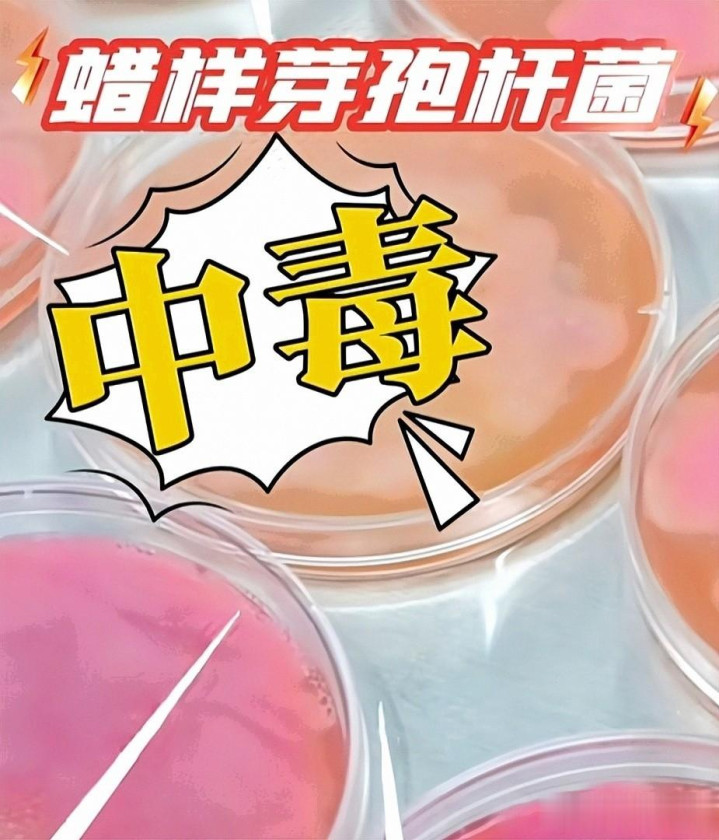

雀巢在多國預防性召回嬰兒配方奶粉,源頭疑為ARA油脂帶入蠟樣芽孢桿菌的嘔吐毒素,常規沖泡也去不掉
這事不是空穴來風
1月5日起,法國先動手,隨后德國、奧地利、丹麥、意大利、瑞典跟進,通知一波接一波

緊接著公司在全球官網把話說透:問題可能來自上游供應商的花生四烯酸油脂(ARA),這東西本該幫寶寶大腦和視網膜發育,如今卻成了危機的入口
截至目前,企業和多國監管都強調尚無與涉事批次相關的疾病報告
這點很關鍵,但對父母來說,心里難免還是一緊
此次召回屬于“預防性、自愿”性質,核心邏輯是寧愿嚴謹,也不冒險
英國食品標準局也給了提醒:cereulide(嘔吐毒素)高度耐熱,按說明沖泡也無法破壞
這就解釋了為何沒出現病例,企業仍然要大范圍動作
實操層面挺繞人的
{jz:field.toptypename/}同款配方在不同國家用不同品牌名:法國是Guigoz/Nidal,德國是BEBA/Alfamino,英國與愛爾蘭叫SMA,其他市場還有NAN

我能想象一個畫面,晚上八點的超市里,年輕爸爸蹲在貨架前翻包裝
拿手機對著批次編號一條條比,背后推車里的寶寶正咬著奶嘴看他
這時候,清晰的批次圖和包裝特征就成了安撫家長的第一條線索
雀巢在各國官網放了圖文說明,算是及時補位
時間線也值得回看
據多方報道
2025年11月底實驗室發現相關線索,12月上旬法國等地已有小范圍召回,但沒明確提到毒素
到了今年1月,隨著檢測推進,企業才把“蠟樣芽孢桿菌相關的細菌源性物質”寫進公告

1月6日,雀巢全球聲明稱已測試所有ARA油脂,并啟用替代供應商
隨后更多國家更新了名單
中國也發布了71個批次的通知,家長可在官網查詢
有組織質疑企業和部分監管在12月初就知情卻延遲擴大行動
FoodWatch的這類說法仍需進一步核實和解釋
說回這個細菌
蠟樣芽孢桿菌廣泛存在于土壤、空氣和塵埃里

它麻煩就麻煩在能產生兩類毒素:嘔吐型和腹瀉型
嬰兒腸道菌群還沒成熟,抵抗力更弱
一旦攝入,可能在短則半小時到五小時內出現惡心、嘔吐、腹瀉,嚴重時帶來脫水與電解質紊亂
更棘手的是它的芽孢有強耐受性
文獻里常見的說法是高溫也難完全滅活,日常巴氏殺菌和40到50℃的沖泡溫度更不夠
所以你會看到企業在沒有病例的情況下仍果斷召回,這不是“多此一舉”,而是“先把閘門關上”
我更關心的是,鏈條到底哪里出了問題

全球能穩產ARA油脂的供應商不到十家,工藝復雜、門檻高,一環松了就可能引來麻煩
污染的路徑通常有三種:生產環境交叉污染、存儲與運輸溫度控制不當、溯源體系有漏洞
放進全球化的坐標里看
當原料跨越多個國家,金沙電玩任何一個環節“打了個盹”,后面的企業與家庭都要替他買單
這不是誰家獨有的痛點,是行業的共同作業題
商業上的沖擊也在發生
多家媒體統計,雀巢股價本周一度下挫約5.7%,公司稱涉事批次占年銷售額遠低于0.5%,財務影響預計有限
有國家的部門把規模形容為“史上最大”
但企業并未證實這一說法,召回覆蓋的國家數量也因統計口徑不同,呈現25到60+不等的范圍
這就是大型事件的現實:傳播跑得快,細節要等
如果你是家長,現在能做的事情其實很明確
先查批次,不確定就別冒險;
保留購物憑證,選擇正規渠道;
關注官網和監管更新
如果寶寶已經食用過相關批次

留意是否出現嘔吐、腹瀉等不適,及時聯系醫生與客服,別慌、別拖
日常里也別迷信“越貴越安全”
配料表、營養成分、生產批號,這些冷冰冰的數字,關鍵時刻是會保護人的
從企業端看,我的直覺是該把“信任但要驗證”變成硬制度
對核心原料做獨立檢測、每批次必檢與留樣,重要供應商實施駐廠監管,縮短鏈路,減少灰區
跨境監管也得走到一起
信息共享、檢測互認,別讓風險在不同國家間打游擊

這些話說了很多年,但每次事件都會提醒我們,所謂“標桿”,真正的價值不在口號,而在流程能經得起一次次放大鏡
有個細節,我一直念叨
不同國家的品牌名差異巨大,家長識別難度陡增,這其實是可以提前設計得更友好的
比如統一的風險標簽體系、相同的批次編碼策略,遇到風浪時可以少走很多彎路
有時候安心來自一句清楚的說明,而不是十頁密密麻麻的術語
食品安全沒有“零風險”,但對嬰兒食品應該“零容忍”
這不是重話,是日常
把復雜的全球鏈條放慢一點,把每一批原料看細一點,才是父母真正的安心

事件還在發酵,名單可能繼續更新,解釋也會更多
但重要的是正視問題、解決問題,別讓信任只停在廣告里
等塵埃落定
希望留下的不只是一次召回的記憶,而是更穩的系統與更快的反應
因為對每個家庭而言
一罐奶粉不是貨架上的商品,而是餐桌上的安心

備案號: